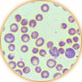
�������ʐ^

原因不明の「免疫介在性溶血性貧血」

illustration:奈路道程
貧血、つまり赤血球の減少の原因にはいろいろあるが、特に犬に多いのが、「免疫介在性溶血性貧血」、ダニにかまれて原虫に感染する「バベシア症」、「タマネギ中毒」などである。
「免疫介在性溶血性貧血」とは難解な名称だが、要するに、本来は、体に侵入した病原菌などを退治する「免疫」が自分の赤血球を破壊する病気だ(溶血性とは血が溶けること)。動物の体では、つねに赤血球や白血球、血小板などが(骨髄で)つくり続けられているが、つくられる赤血球より壊される赤血球の方が多くなれば、貧血となる。原因がわからない「突発性」のものが多い(なかにはウイルス感染に伴って起こる「続発性」のものもある)。アメリカの論文などでは、発情期のメス犬に多いとか、季節的に5,6月ごろに多いとか指摘されているが、シモダ動物病院での調査では、性別、年齢別、季節別での偏りはみられなかった。
治療法としては、犬の免疫を抑えるために、免疫抑制作用のある副腎皮質ホルモンを投与する(それでも治らない場合は抗ガン剤を投与)。症状が重いと、輸血して延命をはかるが、「免疫」によって輸血された血液が破壊され、肝臓や腎臓に悪影響を与えるため、危険性も大きい。一般的に治療後の生存率は8割以上といわれる。早期発見、早期治療によって軽い症状のうちに治療するのが最善である。